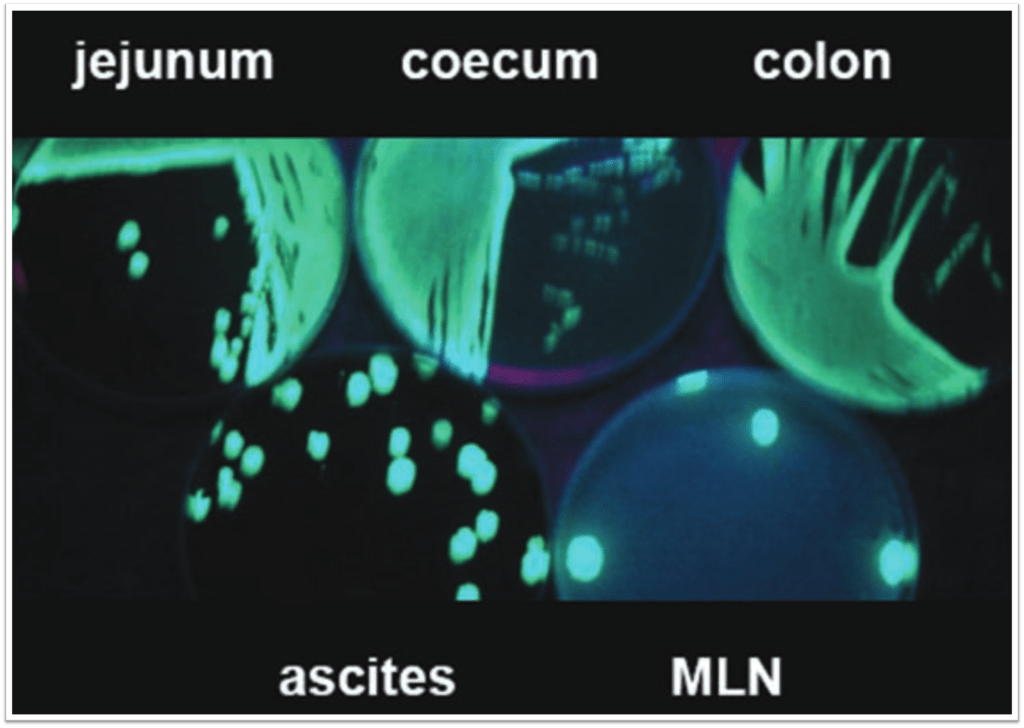

Why does cirrhosis predispose to “bacterial translocation”?
Spontaneous bacterial peritonitis (SBP) is an infection of ascitic fluid without an intra-abdominal surgically-treatable source (e.g., perforated bowel). Although the spontaneous in SBP might suggest this infection of ascitic fluid pops up out of nowhere it is a multifactorial process. And despite the key role of “bacterial translocation”, this is but one of many key events leading to SBP.
In fact, there are at least three relevant factors in cirrhosis that predispose to SBP:
- Intestinal bacterial overgrowth
- Increased intestinal permeability
- Altered immunity
Beginning with intestinal bacterial overgrowth, this has been observed in rat models of cirrhosis and increases in frequency with worsening severity of cirrhosis. In one study, bacterial overgrowth was measured using a breath test after ingestion of glucose. The test was positive in 30% of those with cirrhosis and in none of the controls subjects. And as Child-Pugh score increased, so did the risk of bacterial overgrowth.

Source: Guarner C, Runyon BA, Young S, Heck M, Sheikh MY. Intestinal bacterial overgrowth and bacterial translocation in cirrhotic rats with ascites. J Hepatol 1997;26(6):1372–8.
The question then becomes why. In the human study mentioned above, bacterial overgrowth was more frequent in patients with ascites than in those without ascites. In fact, all but one case of bacterial overgrowth occurred in patients with ascites. The authors speculate that ascites may promote intestinal stasis which may favor abnormal bacterial proliferation. And there are certainly studies suggesting that gut motility is altered in cirrhosis. Whether this is related to enteric or autonomic nervous system dysfunction or elevated levels of glucagon (an inconsistent finding in cirrhosis) isn’t clear.
Beyond dysmotility, other reasons for bacterial overgrowth in cirrhosis include decreased intestinal IgA.
Another key risk factor: use of acid-suppression medications, including proton-pump inhibitors (PPIs). These medications also promote bacterial overgrowth. And although the data do not consistently show an association with SBP, one meta-analysis supports the link with an OR of 3.2.

Beyond stopping a patient’s PPI, adding norfloxacin (and other antibiotics) or pentoxifylline can also reduce bacterial overgrowth. And, unsurprisingly, they have been shown to reduce the risk of SBP.
The next factor that cirrhosis promotes is increased intestinal wall permeability. One study found increased permeability in 42% of those with cirrhosis and just 4% of controls. And, just as was seen with bacterial overgrowth, there was a worsening as the Child-Pugh score increased.

The increased permeability appears to be caused – at least in part – by disruption of intercellular tight junctions in the intestine. Regardless of the exact mechanism, it’s pretty clear that bacteria can make their way across the epithelial barrier of the bowel wall. The question becomes, where do they go next?
Many assume bacteria translocate directly from the gut lumen to the ascites. This isn’t the main route. Instead, in the setting of bacterial overgrowth and increased permeability, bacterial likely translocate to mesenteric lymph nodes (MLNs) first. One study administered green fluorescent protein labeled E. coli orally to cirrhotic rats. These fluorescent bacterial were then found not only in the intestinal lumen but also in the MLNs and ascites.
And translocation to the MLN is more common as the severity of cirrhosis worsens. Bacteria that grow in ascites are the same found in MNL and the cecum. And, the frequency of isolation is typically: cecum > MLN > ascites, suggesting that the MLN are intermediaries.
There is probably one other intermediary: the blood. Though most patients with SBP don’t have positive blood cultures, studies demonstrate genetically similar bacterial DNA in the blood and ascites of patients with cirrhosis. Putting it together, the sequence of events leading to SBP may be: Bacterial overgrowth ➔ Translocation to mesenteric lymph nodes ➔ Bacteremia ➔ Ascites.

Altered immunity likely contributes to many of these events. For example, patients with cirrhosis have diminished activity of the reticuloendothelial system (RES). And the RES system plays an enormous role in the clearance of gram-negative organisms from the blood. So, unsurprisingly, in one study of 41 patients with cirrhosis, it was those with reduced RES function that had an increased risk of bacteremia.
The central role of bacterial translocation across the gut wall is highlighted by the fact that we don’t empirically cover anaerobes in SBP. This is very different from many other abdominal infections (e.g., cholangitis and diverticulitis) where an antibiotic such as metronidazole is included in a regimen even when an anaerobe isn’t isolated.
Original explanations for the paucity of anaerobic SBP centered around the relatively high oxygen concentration of ascites. The idea being that obligate anaerobes simply cannot grow well in such a medium. But more recent data suggest is that anaerobes don’t translocate as well as gram-negative organisms and therefore cause less SBP. This is supported by data showing very little growth of obligate anaerobes in MLNs (figure). As a result, empiric coverage is not required. One reason for the inability of the obligate anaerobes to translocate may be still be their sensitivity to oxygen, though it’s less clear that MLNs have a higher oxygen tension than the gut lumen.

Understanding the chain of events leading to SBP provides insights into other observations about the condition. First, that bacteremia – even when undetected – occurs helps make clear that other infections associated with bacteremia can lead to SBP. These include urinary tract infections, pneumonia, and cellulitis.
The other key point is that cirrhosis is the driver of many steps in the chain leading to SBP. It isn’t just that bacteria translocate. There’s overgrowth, increased permeability, and a poorly functioning immune system. Each contributes to the risk. As a result, you should be cautious making a diagnosis of SBP in patients who have ascites from something other than cirrhosis. There have been very few case reports of SBP in patients with noncirrhotic portal hypertension, nephrotic syndrome, malignant ascites, and cardiac ascites. Of these, the evidence is best for SBP in nephrotic syndrome, particularly in kids. Among the other causes of ascites, SBP does so rarely.
Take Home Points
- Bacterial overgrowth and increased intestinal permeability contribute to the risk of SBP
- Bacteria translocate to mesenteric lymph nodes, then blood, then ascites
- Because cirrhosis contributes to all the factors leading to SBP, it is far and away the most common underlying conition
CME/MOC
Click here to obtain AMA PRA Category 1 Credits™ (1.00 hours), Non-Physician Attendance (1.00 hours), or ABIM MOC Part 2 (1.00 hours).
Listen to the episode
https://oembed.libsyn.com/embed?item_id=22463189
Credits & Citation
◾️Episode and show notes written by Tony Breu
◾️Audio edited by Clair Morgan of nodderly.com
Breu AC, Cooper AZ, Abrams HR. (Trans)locating the bacteria. The Curious Clinicians Podcast. March 16, 2022
Image credit: https://gut.bmj.com/content/71/3/580

Love the podcast! Here’s an episode idea: why beta blockers are used in long QT syndrome, and how the heart rate dependent effect works
LikeLike